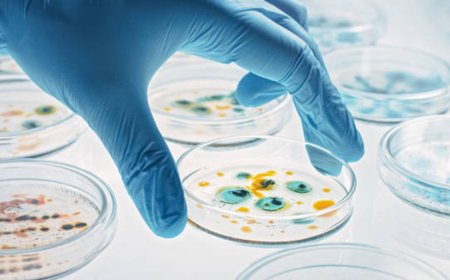
The Impact of Healthcare Technology Solutions on Global Health Trends

Cryptona’s Core Services and Products: Poweri...
cryptona Nov 3, 2025 20
situs toto
AeasGreer1 Nov 1, 2025 9
consultancy in hyderabad for uk studies
sixsigma Apr 21, 2026 1
ReddyBook Bet Builder Feature: Create Custom ...
alex Dec 23, 2025 12
Talentcast.co.uk Guide: Navigating UK Finance...
Abigail Rose Nov 4, 2025 16
Are There Any Benefits of Investing in a Syst...
ambitionfinserve Nov 4, 2025 11
HIPAA Certification in San Diego – Ensuring H...
b2bcert Nov 4, 2025 11
agen slot
CrewFelix2 Nov 4, 2025 11
Find a Prime Showroom for Sale in Arakkonam T...
reeltor01 Nov 4, 2025 13
Electric Shaver for Men: Precision, Comfort, ...
smithp45 Nov 4, 2025 10